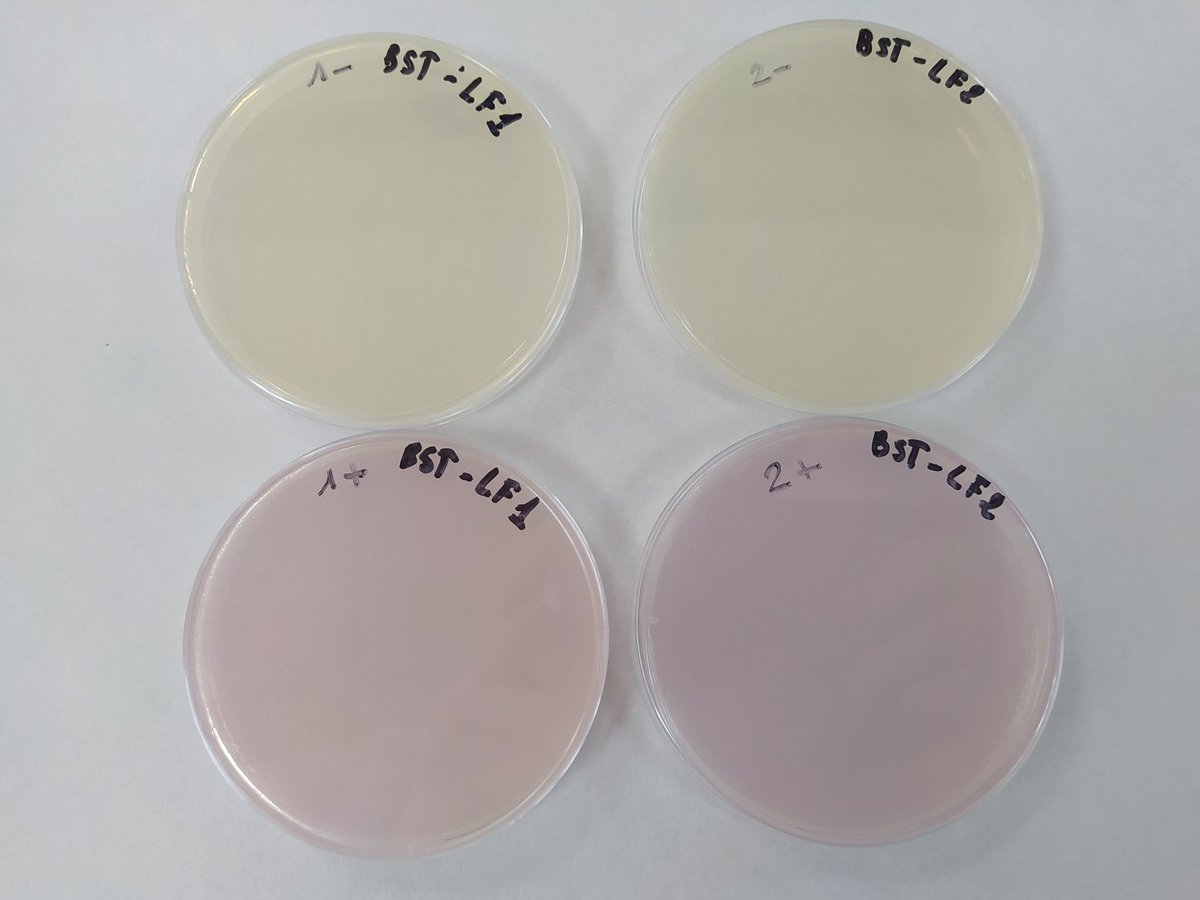
jenny_molloy's tweet image. That sense of relief when your training protocol works in a new lab, in a new country. Happy mCherry-Bst-LF expression &amp;amp; smiles all around @iressef in Dakar, Senegal at @ICGEB #EXPANDIA training
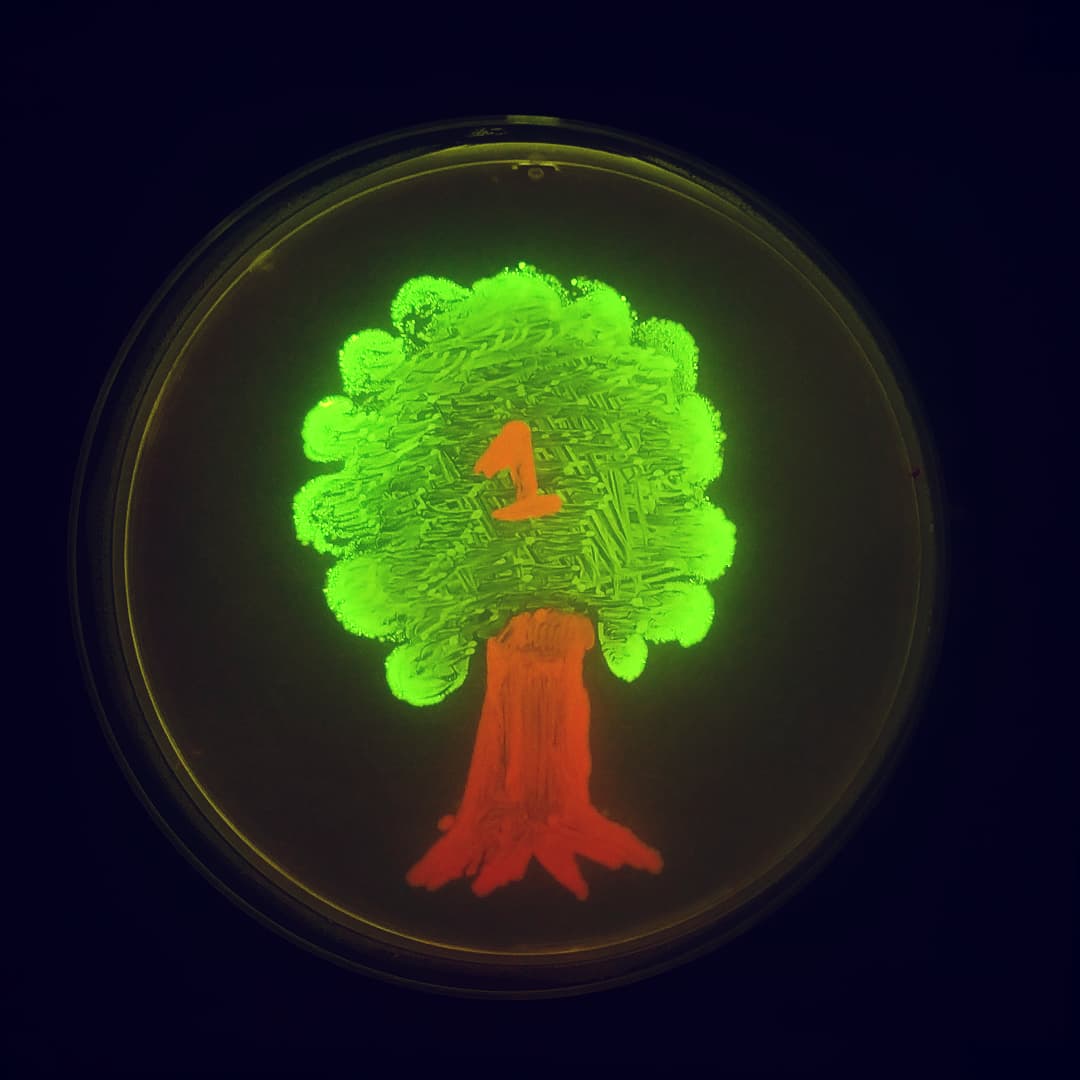
Prosimio_'s tweet image. #OrganismosGeneticamenteModificadosXboric

El apoyo también se siente en este lado de la cordillera. 💪💚 Parte de la manifestación de ayer en el consulado de Chile. "Chileno no bajes la bandera que acá estamos dispuestos a cruzar la cordillera" #ChileSeCanso #PiñeraRenuncia #larinoamerica
Jugadores del Club Deportivo Palestino, de Chile, entraron en la cancha simulando llevar a niños tomados de las manos, una protesta contra el asesinato de más de 15 mil niños en Gaza.
Maravilloso 😍
That sense of relief when your training protocol works in a new lab, in a new country. Happy mCherry-Bst-LF expression & smiles all around @iressef in Dakar, Senegal at @ICGEB #EXPANDIA training

¿Te pasó que en este invierno tuviste no solo una sino incluso dos o tres gripes que te dejaron volteado/a por varios días? No te preocupes, es normal. Abro hilo

Entra al listado de destrucción el Salar de Llamará, ubicado en la Reserva Nacional Pampa del Tamarugal, análogo a la Tierra primitiva, paraíso de la geobiología #litio #salares
En un mes más con el @LabTecLibre haremos un taller en la Universidad Austral dirigido a profesores/as de educación básica y media para llevar la biotecnología a la sala de clase con herramientas abiertas. A ver si Twitter me ayuda a llegar a colegios de la región de los Ríos :)

Reclone Community Meetings are back! Join us on Zoom on 14 Dec at 14:00 GMT, via reclone.org/meetings/ We’ll be getting updates about the Research and DNA Diagnostics Colletion with @jenny_molloy and @MairaRivera

No se que más se podía esperar de esos entes que se definen por montar y abusar de otros seres a punta de látigo.😡 (digo entes y no animales para no ofender al resto del reino) #Ciclistas #HuasosAsesinos #AprueboXlosAnimales
Gravísimo los #huasosculiaos del rechazo pegándole latigazos a mujeres ciclistas a vista y paciencia de carabineros de Chile, esto no puede quedar impune. #Apruebo4deSeptiembre #apruebo
🔴 Registro da cuenta cómo @Carabdechile bloquea el paso a ciclistas que perseguían a carreta que atropelló a participantes de cicletada por el Apruebo. (vía @max_themind)
¡Atentos a #Spotify! Hoy nace “Decidimos”, un podcast sobre ciencia, conocimientos y mujeres en el proceso constituyente @salazar_maite investigadora @iBioChile es parte de esta iniciativa. ¡Aquí la puedes escuchar! ➡️ open.spotify.com/show/4Q5aCWQ87… @CentrosAnid @Decidimos_

Leí el borrador de la NC y tiene premisas prometedoras para las comunidades que trabajamos en ciencias e investigación.
Que emoción 。◕‿◕。!! Felicidades Broto!
Golden Gate Assembly protocols.io/view/golden-ga… Golden Assembly protocol ready 👌 #DNAassembly #Synbio
protocols.io
Golden Gate Assembly
The Golden Gate technique allows the assembly of genetic sequences from libraries of standardized basic components, which are cleaved from their donor vectors and concatenated i...
(1/n)🧵 FluoPi es un proyecto colaborativo creado por miembros de @ucatolica y @BackyardBrains que busca implementar un sistema de imageneologia de fluorescencia múltiple! GMI decidió construir y adaptar este proyecto a las necesidades del grupo 🧫🔬 #Microscopy #microbiology

Llanto del desarrollismo sustentable: "No existe país con vida digna sin las actividades que quiere prohibir el ambientalismo falopa. Necesitamos dólares, trabajo, mejores salarios..." La realidad: El hambre y la contaminación son de nosotros, las divisas son ajenas.

Estamos levantando está maravillosa propuesta para garantizar el acceso a la ciencia y tecnología desarrollada con fondos públicos. Es decir, que lo generado sea libre y contribuya al dominio público. Dele una mirada, y porque no, su patrocinio ✨ #IniciativaPopularDeNorma
Con distintos activistas por el conocimiento libre, estamos proponiendo que las investigaciones y conocimientos tecnológicos desarrollados con fondos públicos queden de libre acceso para que toda la sociedad se pueda beneficiar. Apoya nuestra iniciativa! plataforma.chileconvencion.cl/m/iniciativa_p…

No creí que viviría para este momento 😱
Hoy estaremos charlando sobre herramientas abiertas para la ciencia en el Ciclo de Seminarios Virtuales 2021 del @iBioChile bit.ly/3FMFI5A
ibio.cl
Seminario invita conversar sobre la soberanía tecnológica: próximo encuentro se realizará el 24 de...
4 seminarios gratuitos con especialistas de Chile, Perú, Argentina, México y Chile presentan interesantes miradas y comparten sus conocimientos en el ciclo 2021 “Hacia la soberanía Tecnológica:...
HOY: Seminario invita conversar sobre la soberanía tecnológica: próximo encuentro se realizará el 24 de noviembre 2021 vía ZOOM bit.ly/3FMFI5A #Tecnologia #ciencia #Chile #Perú #Argentina #México #seminario @CentrosAnid @SeremiCienciaN @SeremiCienciaAu @openacces

United States トレンド
- 1. LeBron 78.1K posts
- 2. #DWTS 52.8K posts
- 3. #LakeShow 3,765 posts
- 4. Whitney 15.9K posts
- 5. Peggy 18K posts
- 6. Reaves 8,028 posts
- 7. Keyonte George 1,844 posts
- 8. Celebrini 4,680 posts
- 9. Orioles 6,883 posts
- 10. Jazz 27.2K posts
- 11. Elaine 17.4K posts
- 12. Grayson 6,986 posts
- 13. Taylor Ward 3,493 posts
- 14. #TheFutureIsTeal 1,503 posts
- 15. Dylan 25.1K posts
- 16. #Lakers 1,608 posts
- 17. Haiti 61.3K posts
- 18. Tatum 16K posts
- 19. #WWENXT 16.9K posts
- 20. Angels 32.2K posts
Something went wrong.
Something went wrong.